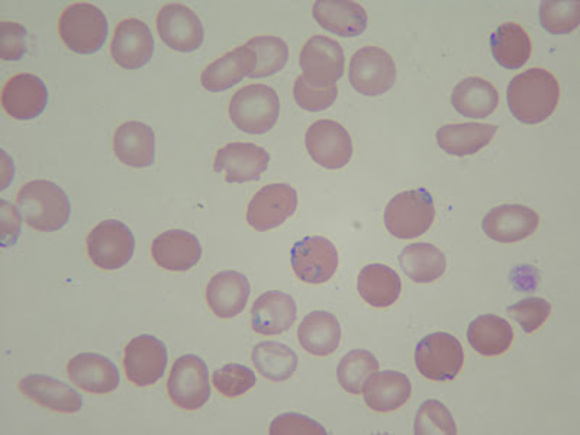

Meet your Posher, Waseem
$0
Size
Not for sale
Like and save for later
Hi! I'm Waseem. Some of my favorite brands are J. Crew, American Eagle Outfitters, Nike, and Free People. Thanks for stopping by! Feel free to leave me a comment so that I can check out your closet too. :)
Shipping/Discount
Trending Now
Find Similar Listings
Account is under Review
Comment posting is temporarily restricted. Our team will reach out to you shortly. To understand why, select
Learn More.